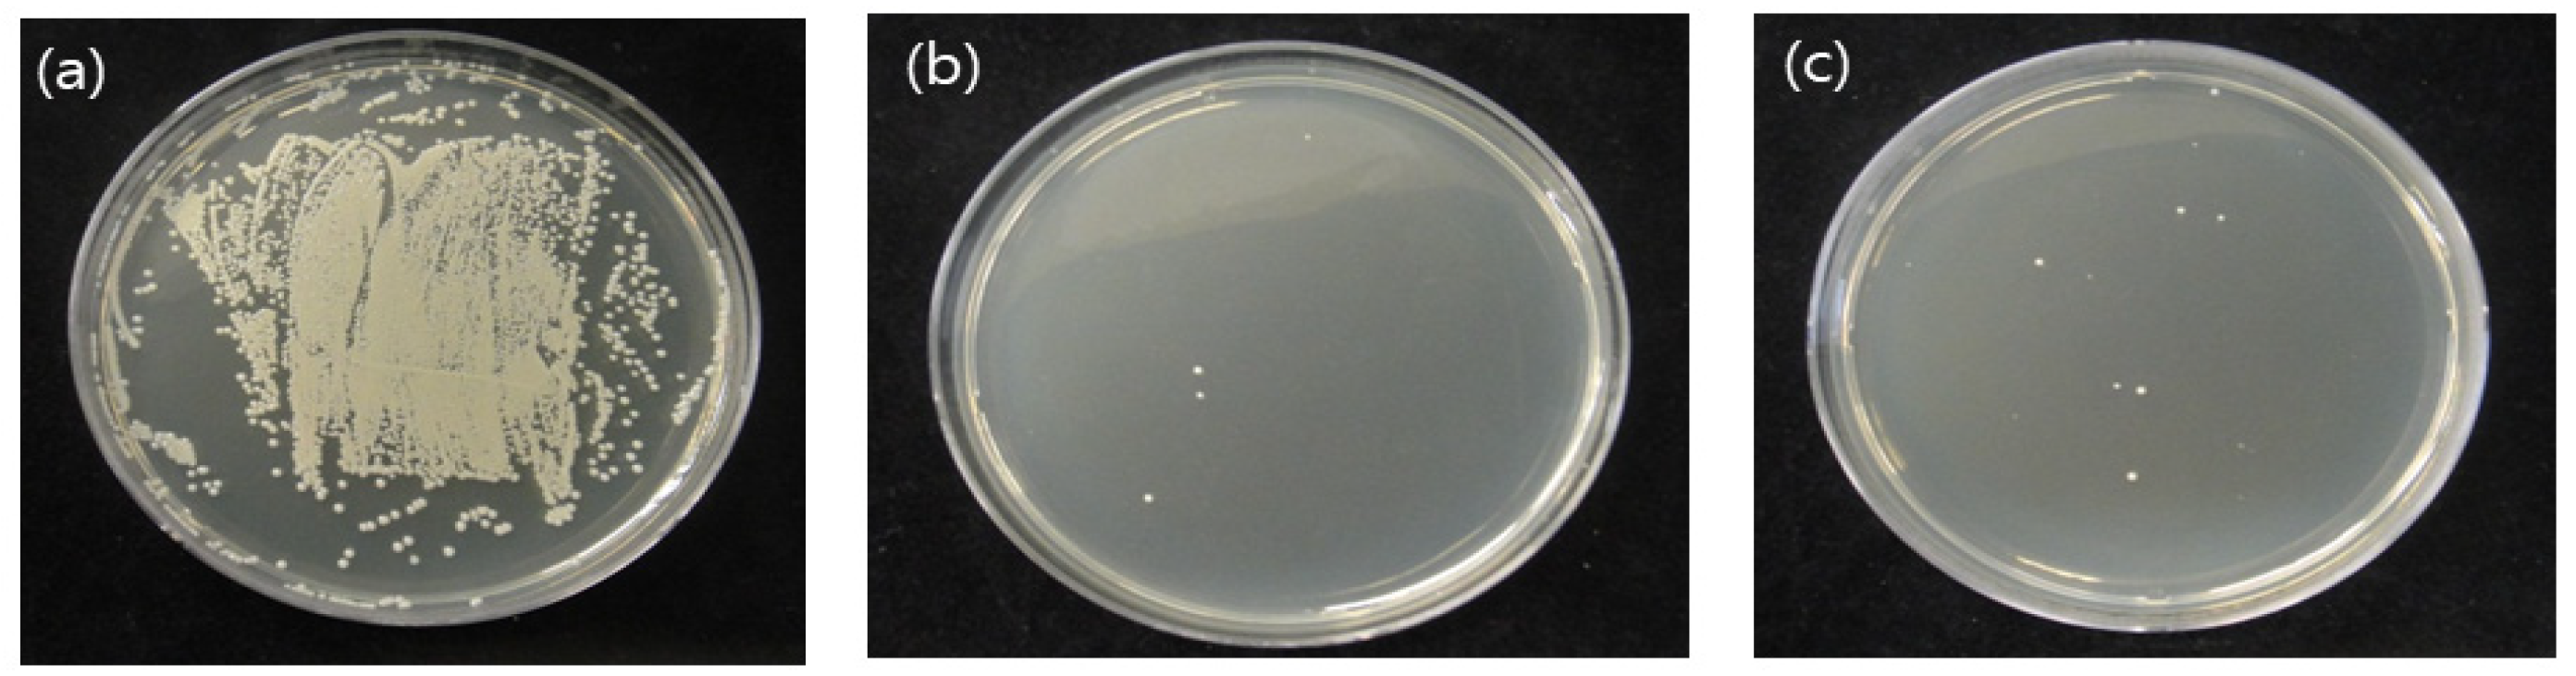
Medicina 58 01556 g002

Surface Characterization, Antimicrobial Activity of Nonthermal Atmospheric-Pressure Plasma Jet on Polyvinyl Siloxane Impression Materials
Abstract
:1. Introduction
2. Materials and Methods
2.1. Sample Preparation
2.2. NAPPJ Treatment
2.3. Microbial Culture
2.4. Evaluation of Bacterial Colony Forming Units (CFUs)
2.5. Morphology of S. mutans
2.6. Surface Chemistry
2.7. Contact Angle Measurement
2.8. Surface Roughness
2.9. Strain-in-Compression Tests
2.10. Detail Reproduction Test
2.11. Statistical Analysis
3. Results
3.1. CFUs of S.mutans
3.2. Morphology of S. mutans
3.3. Surface Chemistry
3.4. Contact Angle Measurement
3.5. Surface Roughness
3.6. Strain-in-Compression Tests
3.7. Detail Reproduction Test
4. Discussion
5. Conclusions
Author Contributions
Funding
Institutional Review Board Statement
Informed Consent Statement
Data Availability Statement
Acknowledgments
Conflicts of Interest
References
- Azevedo, M.J.; Correia, I.; Portela, A.; Sampaio-Maia, B.A. Simple and effective method for addition silicone impression disinvectin. Adv. Prosthodont. 2019, 11, 155–161. [Google Scholar] [CrossRef] [PubMed] [Green Version]
- Drennon, D.G.; Johnson, G.H.; Powell, G.I. The accuracy and efficacy and efficacy of disinfection by spray atomization on elastomeric impressions. J. Prosthet. Dent. 1989, 62, 468–475. [Google Scholar]
- Alain, T.; Etaienne, D.; Alain, I.; Pascal, B. Dimensional stability of seven elastomeria impression materials immersed in disinfectiants. J. Prosthet. Dent. 1996, 76, 8–14. [Google Scholar]
- Frederick, A.; Eugene, B. Sodium hypochlorite disinfection of irreversible hydrocolloid impression material. J. Prosthet. Dent. 1992, 67, 628–631. [Google Scholar]
- Huang, Y.R.; Hung, Y.C.; Hsu, S.Y.; Huang, Y.W.; Hwang, D.F. Application of electrolyzed water in the industry. Food Control 2008, 19, 329–345. [Google Scholar] [CrossRef]
- John, O.; David, J. Preliminary results from disinfection of irreversible hydrocolloid impressions. J. Prosthet. Dent. 1990, 63, 701–707. [Google Scholar]
- Vasilets, V.N.; Gutsol, A.; Shekhter, A.B.; Fridman, A. Plasma medicine. High Energy Chem. 2009, 43, 229–233. [Google Scholar] [CrossRef]
- Jeong, W.S.; Kwon, J.S.; Lee, J.H.; Uhm, S.H.; Ha Choi, E.; Kim, K.M. Bacterial attachment on titanium surfaces is dependent on topography and chemical changes induced by nonthermal atmospheric pressure plasma. Biomed. Mater 2017, 26, 045015. [Google Scholar] [CrossRef]
- Sung, S.J.; Huh, J.B.; Yun, M.J.; Chang, B.M.W.; Jeong, C.M.; Jeon, Y.C. Sterilization effect of atmospheric pressure non-thermal air plasma on dental instruments. J. Adv. Prosthodont. 2013, 5, 2–8. [Google Scholar] [CrossRef] [PubMed] [Green Version]
- Ch, S.K.; Sarada, P.; Ch, S.R.; Reddy, S.; Nagasailaja, D.S.V. Plasma torch toothbrush a new insight in fear free dentisry. J. Clin. Diagn. Res. 2014, 8, ZE07. [Google Scholar] [CrossRef] [PubMed]
- Lloyd, G.; Friedman, G.; Jafri, S.; Schultz, G.; Fridman, A.; Harding, K. Review: Gas plasma: Medical uses and developments in wound care. Plasma Process. Polym. 2010, 7, 194–211. [Google Scholar] [CrossRef]
- Lee, M.J.; Kwon, J.S.; Jiang, H.B.; Choi, E.H.; Park, G.; Kim, K.M. The antibacterial effect of non-thermal atmospheric pressure plasma treatment of titanium surfaces according to the bacterial wall structure. Sci. Rep. 2019, 9, 1938. [Google Scholar] [CrossRef] [Green Version]
- Pan, J.; Sun, K.; Liang, Y.; Sun, P.; Yang, X.; Wang, J.; Zhang, J.; Zhu, W.; Fang, J.; Becker, K.H. Cold plasma therapy of a tooth root canal infected with Enterococcus faecalis biofilms In Vitro. J. Endodont. 2013, 39, 105–110. [Google Scholar] [CrossRef] [PubMed]
- Fridman, G.; Brooks, A.D.; Balasubramanian, M.; Fridman, A.; Gutsol, A.; Vasilets, V.N.; Ayan, H.; Friedman, G. Comparison of direct and indirect effects of non-thermal atmospheric-pressure plasma on bacteria. Plasma Process. Polym. 2007, 4, 370–375. [Google Scholar] [CrossRef]
- Fridman, G.; Peddinghaus, M.; Ayan, H.; Fridman, A.; Balasubramanian, M.; Gutsol, A.; Brooks, A.; Friedman, G. Blood coagulation and living tissue sterilization by floating-electrode dielectric barrier discharge in air. Plasma Chem. Plasma Process. 2006, 26, 425–442. [Google Scholar] [CrossRef]
- Choi, Y.R.; Kwon, J.S.; Song, D.H.; Choi, E.H.; Lee, Y.K.; Kim, K.N.; Kim, K.M. Surface modification of biphasic calcium phosphate scaffolds by non-thermal atmospheric pressure nitrogen and air plasma treatment for improving osteoblast attachment and proliferation. Thin Solid Film. 2013, 547, 235–240. [Google Scholar] [CrossRef]
- Owen, C.P.; Goolam, G. Disinfection of impression materials to prevent viral cross contamination: A review and a protocol. Int. J. Prosthodont. 1993, 6, 480–494. [Google Scholar] [PubMed]
- Rentzia, A.; Coleman, D.C.; O’Donnell, M.J.; Dowling, A.H.; O’Sullivan, M. Disinfection procedures: Their efficacy and effect on dimensional accuracy and surface quality of an irreversible hydrocolloid impression material. J. Dent. 2011, 39, 133–140. [Google Scholar] [CrossRef] [PubMed]
- Milward, P.J.; Phil, M.; Waters, M.G. The effect of disinfection and a wetting agent on the wettability of addition polymerized silicone impression materials. J. Prosthet. Dent. 2011, 86, 165–167. [Google Scholar] [CrossRef]
- Jagger, D.C.; Al Jabra, O.; Harrison, A.; Vowles, R.W.; McNally, L. The effect of a range of disinfectants on the dimensional accuracy of some impression materials. Eur. J. Prosthodont. Restor. Dent. 2004, 12, 154–160. [Google Scholar]
- Moore, G.L. Introduction to Inductively Coupled Plasma-Atomic Emission Spectrometry; Elsevier Science Co.: Amsterdam, The Netherlands, 2004. [Google Scholar]
- Boscariol, M.R.; Moreira, A.J.; Mansano, R.D.; Kikuchi, I.S.; Pinto, T.J.A. Sterilization by pure oxygen plasma and by oxygen. hydrogen peroxide plasma: An efficacy study. Int. J. Pharm. 2008, 353, 170–175. [Google Scholar] [CrossRef] [PubMed]
- Yoo, E.-M.; Choi, Y.-R.; Kang, M.-K. Antimicrobial Efficacy of Nitrogen-Based Non-thermal Atmospheric Pressure Plasma Jet on Dental Biofilm. Iran. J. Sci. Technol. Trans. A Sci. 2020, 44, 1541–1547. [Google Scholar] [CrossRef]
- Yamazaki, H.; Ohshima, T.; Tsubota, Y.; Yamaguchi, H.; Jayawardena, J.A.; Nishimura, Y. Microbicidal activities of low frequency atmospheric pressure plasma jets on oral pathogens. Dent. Mater. J. 2011, 30, 384–391. [Google Scholar] [CrossRef] [Green Version]
- Park, B.J.; Lee, D.H.; Park, J.C. Sterilization using a microwave-induced argon plasma system at atmospheric pressure. Phys. Plasmas 2003, 10, 4539–4544. [Google Scholar] [CrossRef]
- Kong, M.G.; Kroesen, G.; Morfill, G.; Nosenko, T.; Shimizu, T. Plasma medicine: An introductory review. New J. Phys. 2009, 11, 2–36. [Google Scholar] [CrossRef]
- Zamperini, C.A.; Machado, A.L.; Vergani, C.E.; Pavarina, A.C.; Giampaolo, E.T.; Cruz, N.C. Adherence in vitro of Candida albicans to plasma treated acrylic resin. Effect of plasma parameters, surface roughness and salivary pellicle. Arch. Oral Biol. 2010, 55, 763–770. [Google Scholar] [CrossRef] [PubMed]
- Goree, J.; Liu, B.; Drake, D.; Stoffels, E. Killing of S. mutans bacteria using a plasma needle at atmospheric pressure. IEEE Trans. Plasma Sci. 2006, 34, 1317–1324. [Google Scholar] [CrossRef] [Green Version]
- Hayashi, R.; Ueno, T.; Migita, S.; Tsutsumi, Y.; Doi, H.; Ogawa, T.; Hanawa, T.; Wakabayashi, N. Hydrocarbon deposition attenuates osteoblast activity on titanium. J. Dent. Res. 2014, 93, 698–703. [Google Scholar] [CrossRef] [Green Version]
- Choi, S.H.; Jeong, W.S.; Cha, J.Y.; Lee, J.H.; Yu, H.S.; Choi, E.H.; Kim, K.M.; Hwang, C.J. Time-dependent effects of ultraviolet and nonthermal atmospheric pressure plasma on the biological activity of titanium. Sci. Rep. 2016, 6, 33421. [Google Scholar] [CrossRef]
- Korshunov, S.S.; Imlay, J.A. A potential role for periplasmic superoxide dismutase in blocking the penetration of external superoxide into the cytosol of gram-negative bacteria. Mol. Microbiol. 2002, 43, 95–106. [Google Scholar] [CrossRef]
- DeWald, J.P.; Nakajima, H.; Schniederman, E.; Okabe, T. Wettability of impression materials treated with disinfectants. Am. J. Dent. 1992, 5, 103–108. [Google Scholar] [PubMed]
- Al-Omari, W.M.; Jones, J.C.; Wood, D.J. The effect of disinfecting alginate and addition cured silicone rubber impression materials on the physical properties of impression and resultant casts. Eur. J. Prosthodont. Restor. Dent. 1998, 6, 103–110. [Google Scholar] [PubMed]
- Yapp, R.; Baumann, A.; Powers, J.M. Properties of elastomeric impression materials. Dent. Advis. 2014, 31, 1. [Google Scholar]
- ISO 4823; Elastomeric impression materials. International Organization for Standardization: Geneva, Switzerland, 2000.
- Norling, B.K.; Reisbick, M. The effect of nonionic surfactants on bubble entrapment in elastomeric impression materials. J. Prosthet. Dent. 1979, 42, 342–347. [Google Scholar] [CrossRef]
- Daou, E.E. The elastomers for complete denture impression: A review of the literature. Saudi Dent. J. 2010, 22, 153–160. [Google Scholar] [CrossRef]

Publisher’s Note: MDPI stays neutral with regard to jurisdictional claims in published maps and institutional affiliations. |
© 2022 by the authors. Licensee MDPI, Basel, Switzerland. This article is an open access article distributed under the terms and conditions of the Creative Commons Attribution (CC BY) license (https://creativecommons.org/licenses/by/4.0/).
Share and Cite
Choi, Y.-R.; Yoo, E.-M.; Seo, H.-Y.; Kang, M.-K. Surface Characterization, Antimicrobial Activity of Nonthermal Atmospheric-Pressure Plasma Jet on Polyvinyl Siloxane Impression Materials. Medicina 2022, 58, 1556. https://doi.org/10.3390/medicina58111556
Choi Y-R, Yoo E-M, Seo H-Y, Kang M-K. Surface Characterization, Antimicrobial Activity of Nonthermal Atmospheric-Pressure Plasma Jet on Polyvinyl Siloxane Impression Materials. Medicina. 2022; 58(11):1556. https://doi.org/10.3390/medicina58111556
Chicago/Turabian StyleChoi, Yu-Ri, Eun-Mi Yoo, Hye-Yeon Seo, and Min-Kyung Kang. 2022. "Surface Characterization, Antimicrobial Activity of Nonthermal Atmospheric-Pressure Plasma Jet on Polyvinyl Siloxane Impression Materials" Medicina 58, no. 11: 1556. https://doi.org/10.3390/medicina58111556





